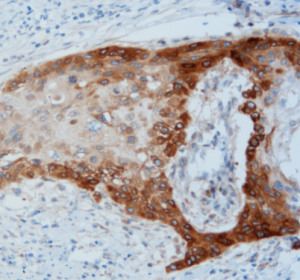
EnVision Flex + Mouse Linker detection - D2-40

MicroStacker™ Polymer Detection System is a biotin-free, polymeric horseradish peroxidase (HRP)- secondary antibody conjugate system for the detection of mouse and rabbit primary antibody on formalin-fixed, paraffin-embedded (FFPE) tissues in an immunohistochemistry (IHC) procedure. The innovative MicroStacker™ technology allows well-controlled layered stacking of antibodies and peroxidase enzymes on a micro-polymer scaffold. This technique results in a compact polymeric structure that easily penetrates to all cellular compartments. Plus, the system utilizes F(ab’) fragments of IgG secondary antibody instead of the whole IgG, which avoids the background caused by non-specific binding of whole IgG to endogenous Fc receptors. Compared to the MicroStacker™ Polymer Detection System, Universal, the Enhanced kit comes with the HRP polymer at a higher degree of polymerization, thus higher sensitivity.
MicroStacker™ Enhanced is a biotin-free polymer-based HRP secondary antibody detection system optimized for formalin-fixed paraffin-embedded (FFPE) tissue sections. It’s designed to detect mouse and rabbit primary antibodies in IHC workflows.
Compared to the standard MicroStacker™ Universal kit, the Enhanced version features a higher degree of polymerization, offering greater sensitivity and improved signal intensity.
Use TBS-T or PBS-T as wash buffer. Store reagents at 2–8°C. Do not freeze.

REAL EnVision™

MicroStacker™ Universal

MicroStacker™ Enhanced

REAL EnVision™
EnVision™ Flex + Mouse Linker

MicroStacker™ Enhanced
| Cat # | Product Name | Size | Components |
|---|---|---|---|
| SD3206 | MicroStacker™ Polymer Detection Kit, Enhanced, 2-Step (4 components) | 200T, 1000T |
1 Linker,Rabbit-anti-Mouse 2 Anti-Rabbit HRP-Polymer 3 DAB Chromogen (20x) 4 DAB Substrate Buffer |
| SD3207 | MicroStacker™ Polymer Detection Kit, Enhanced, 2-Step (5 components) | 200T, 1000T |
1 Linker,Rabbit-anti-Mouse 2 Anti-Rabbit HRP-Polymer 3 DAB Chromogen (20x) 4 DAB Substrate Buffer 5 Peroxidase Block |
| SD3208 | MicroStacker™ Polymer Detection Kit, Enhanced, 2-Step (6 components) | 200T, 1000T |
1 Linker,Rabbit-anti-Mouse 2 Anti-Rabbit HRP-Polymer 3 DAB Chromogen (20x) 4 DAB Substrate Buffer 5 Peroxidase Block 6 Hematoxylin |